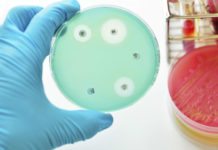
Platinea får 40 miljoner under fem år Läkemedelsvärlden

Innovationsmyndigheten Vinnova tappar sin nuvarande generaldirektör Charlotte Brogren. Det meddelar regeringen via näringsdepartementet i ett pressmeddelande.
Efter drygt åtta år som chef för myndigheten går nu Charlotte Brogren till industrikoncernen Alimak group, där hon blir utvecklingschef. Alimak group utvecklar och levererar vertikala transportlösningar för bygg- och industrisektorn.
I ett uttalande på Vinnovas hemsida beskriver Charlotte Brogren arbetsbytet som ett sätt att leva som hon lär.
– Jag tycker att det behövs mer rörlighet mellan offentlig och privat verksamhet och jag vill leva som jag lär, säger Charlotte Brogren.
Den 9 oktober är Charlotte Brogrens sista dag på Vinnova. Därefter tar Leif Callenholm över som tillförordnad generaldirektör tills en ny generaldirektör utsetts av regeringen. Leif Callenholm är sedan 2009 anställd som förvaltningsdirektör och ställföreträdande generaldirektör för interna frågor på Vinnova.